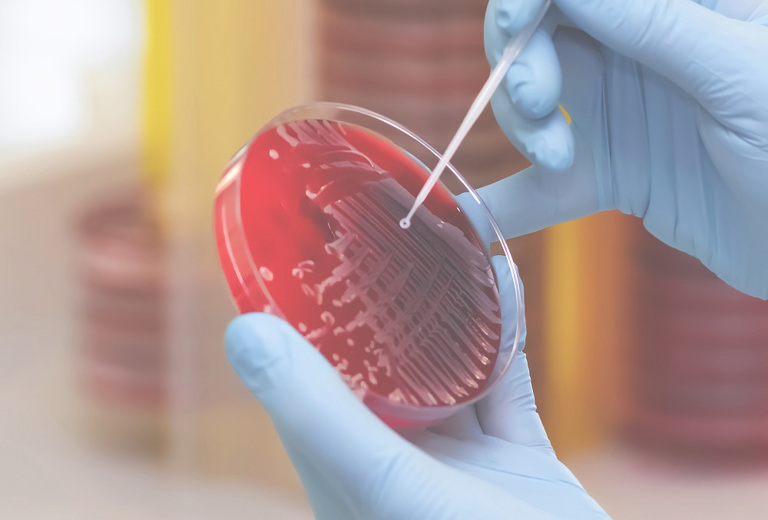
einsender

Veranstaltungen
Das Labor Deutscher Platz Leipzig bietet Ihnen in regelmäßigen Abständen Fortbildungsveranstaltungen für Ärztinnen und Ärzte sowie auch für med. Praxispersonal an. Unsere Fortbildungsveranstaltungen für Ärzte werden durch die Landesärztekammer mit CME-Fortbildungspunkten zertifiziert.
Für die Teilnahme an unseren Fortbildungsveranstaltungen ist eine Anmeldung erforderlich.
Veranstaltungskalender: